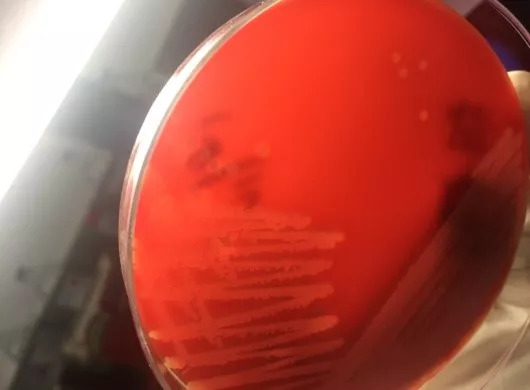

2018-02-07 15:09
作者 黄小华 宁永忠

患者,男,56岁,主因“烧伤后全身大范围皮肤渗液一月余”,由门诊拟“重度烧伤”于2017年11月28日入院。
病例特点
1. 中年男性,有确切烧伤病史。
2. 症见:全身大范围皮肤渗液。
3. 体格检查:体温37.1℃ 脉搏:75次/分 呼吸:21次/分 血压142/75mmHg。头、面部、四肢可见大范围皮肤渗液、可见大量肉芽组织生长,周围可见痂壳及新生长的暗红色皮肤;下肢大腿内侧可见规则色素沉着区;双侧指关节肿胀,可见大量肉芽组织生长,屈曲受限。
辅助检查
肝功、肾功、电解质正常,血糖6.92mmol/L,血常规WBC4.71×10^9/L,中性粒百分比46.9%,尿蛋白1+
诊断
1. 重度烧伤
2. 双侧上肢植皮术后
患者诉创面枯痛,可见新鲜上皮组织生长,右前臂创面稍显湿润,表皮破损,可见分泌物。
微生物学鉴定
12月4日送检标本为右前臂创面分泌物。
分泌物接种血平板和麦康凯平板,血平板上白色不溶血(对光亦无溶血)菌落4+,涂片为革兰阳性球菌,触酶阳性,凭经验觉得是凝固酶阴性葡萄球菌CNS,按皮肤表面定植菌理解,不处理;麦康凯上菌落,氧化酶阳性,疑似铜绿,上机鉴定。
血平板上阳性球菌4+,疑似铜绿的菌落1+。

图1. 24小时菌落,白色,无溶血环

图2. 48小时菌落,略微偏黄,无溶血环

图3. 72小时菌落,略微偏黄,无溶血环;一区有铜绿假单胞菌菌落
图4. 传代培养24小时后,将平板置于4℃冰箱,24小时后菌落轻微溶血

图5. 将平板置于4℃冰箱,7日后菌落溶血圈增大
因带教实习,做了试管法血浆凝固酶,24小时后结果阳性(作者当时觉得出乎意料)。又做玻片法,也是阳性。上机鉴定,结果为金黄色葡萄球菌(贝克曼Walk Away96细菌鉴定仪,鉴定率90.1%,耐甲氧西林),另一个菌为铜绿假单胞菌(鉴定率99.9%耐碳青霉烯类)。
治疗
入院前一月外院抗生素使用史不详。入院初未使用抗生素,6天后创面分泌物送检,头孢西丁钠静滴。12月8日改为头孢他啶。
讨论
本病例因为菌落无溶血,产黄色色素不明显,差点漏检。如果漏检,将直接导致临床用药的偏离,还会导致多重耐药菌未及时隔离而在院内传播的风险(当然在MRSA已经流行的背景下,这个风险意义不大)。
此外,本例凸显了按流程操作的重要性——涂片染色、触酶、血浆凝固酶、上机生化鉴定缺一不可。经验是不完全可靠的,一切要靠证据说话。
另:医生根据药敏结果修正头孢西丁为头孢他啶,但显然没重视MRSA。跟医生沟通,医生说等等看,截至笔者初稿完成,医嘱仍未改动。
此例还有值得关注的一点是,入院六天的分离株即MRSA与CRPA共存。感控意识和措施亟需加强,经验治疗当有所虑,而实验室培养当有所预。
建议
一、对金黄色葡萄球菌病原谱占比很高标本(比如SSTI时皮肤标本),或正常无菌部位标本(血液、脑脊液、胸腹水、关节液、心包积液、组织等),或可以定量培养而分离株浓度超过阈值的标本(如BALF、血管内导管、尿液),直觉为CNS的分离株,应该规范鉴定到种。这样做的意义有三层:
1. 可以捕捉不典型的金黄色葡萄球菌。该菌毒性强,是最重要的条件致病菌之一,不应漏检;
2. 可以捕捉有重要意义的其他葡萄球菌,如路邓葡萄球菌等。
3. 即便是普通CNS,也有致病可能。比如血液分离株,国际上认为10%有意义。实验室要认真报告,临床要认真分析。不能一看CNS,实验室说污染污染,不鉴定,甚至报无菌生长。而医生一看CNS也说污染污染,不加分析、不予思考,甚至病程记录不着笔墨。
二、对咳痰或抽吸痰标本,一般情况下不报告CNS(例外是48hr看羊血平皿为3+以上的纯生长。笔者按,非常罕见、不能泛化)。此时建议用快速试验来区分CNS与金葡菌。对肺炎患者,金葡菌半定量超过正常菌群时,其阳性预测值在50%左右,需要回报临床。不能漏检。
三、一般性的腹泻患者、粪便标本,一般情况下不必筛查金葡菌。故不典型金葡不必考虑。
四、一般而言,包括金黄色葡萄球菌在内,葡萄球菌都有定植导致的采集污染的可能。这需要在临床层面综合判断。前提自然是实验室不会漏检。漏检,则一切都无从谈起。
本文的目的是想提醒各位微生物学同仁重视不典型金葡菌(不溶血或溶血弱、无色素或色素弱)的分离鉴定,避免漏检。
背景知识
查MCM11
1. 英文p358表2(中文p430),金黄色葡萄球菌金黄亚种对应的菌落色素是+、溶血素是+。这意味着二者的概率都在90%或更高。不产生色素、无溶血的金葡只有个位数百分比。
2. 英文P362正文(中文p440),提到典型菌落是有色素、有溶血。溶血为hazy or distinct,就是模糊的或清晰的,没有涉及无溶血、双层溶血等。色素是在白、灰白的基础上有黄的颜色,从黄到橙不等(此处中文翻译与英文有细节不同)。没有提无色素情况。特殊菌落提到粘液型、微小变异。显然微小变异是重点。
Pubmed:笔者简单检索,没有找到完全不溶血金葡的相关文章,待日后进一步精细查找。相关类似文章有报道不完全溶血的情况。比如近期一篇文献(Front Cell Infect Microbiol. 2016 Nov 18;6:146.)是国人报道——苏州大学杜鸿教授团队。2013-2015年苏州大学第二附属医院共60株不完全溶血表型(Incomplete Hemolytic Phenotype,IHP)。文章提到和彻底溶血不同,但并没有明确定义IHP。而数量如此之多,也值得我们关注。
初稿给陈宏斌老师审阅。陈老师校正细务的同时,提示关注hVISA和SCV(二者可以无溶血)。笔者醍醐灌顶,竟然漏了hVISA。查pubmed可见:
1、 SCV指微小变异菌落,见于多个菌种,1910年即有发现。此处特指金黄色葡萄球菌,有的溶血减弱,有的无溶血。见图6(无溶血)。金葡菌SCV和慢性感染、胞内感染有关。因为菌落小、生长慢,实验室容易漏检。笔者阅读文献,理解SCV应该不是单一的群体,不同原因都可以导致这一表型。不知道是否正确,待方家。

图6. 金黄色葡萄球菌微小变异菌落(SCV)
2、有文章(J Clin Microbiol. 2012 May;50(5):1742-4.)提供了美图(见图7)。图中A和B是VSSA,δ溶血;C是hVISA,不溶血。D是VISA,不溶血。 并由此现象设计了筛选hVISA的方式(Diagn Microbiol Infect Dis. 2015 Apr;81(4):246-50.)。由此可知,不溶血葡萄球菌,不仅仅有诊断层面的意义,还有治疗层面的启示。亲,你关注了吗?

图7. 金黄色葡萄球菌hVISA
大家多多批评!
投稿人:黄小华 重庆市云阳县中医院
宁永忠 清华大学附属垂杨柳医院
责任编辑:陈宏斌 北京大学人民医院
以上文章为京港感染论坛独家编辑,转载需要获得许可,并标明来源,投稿热 线:pidmic@126.com。


